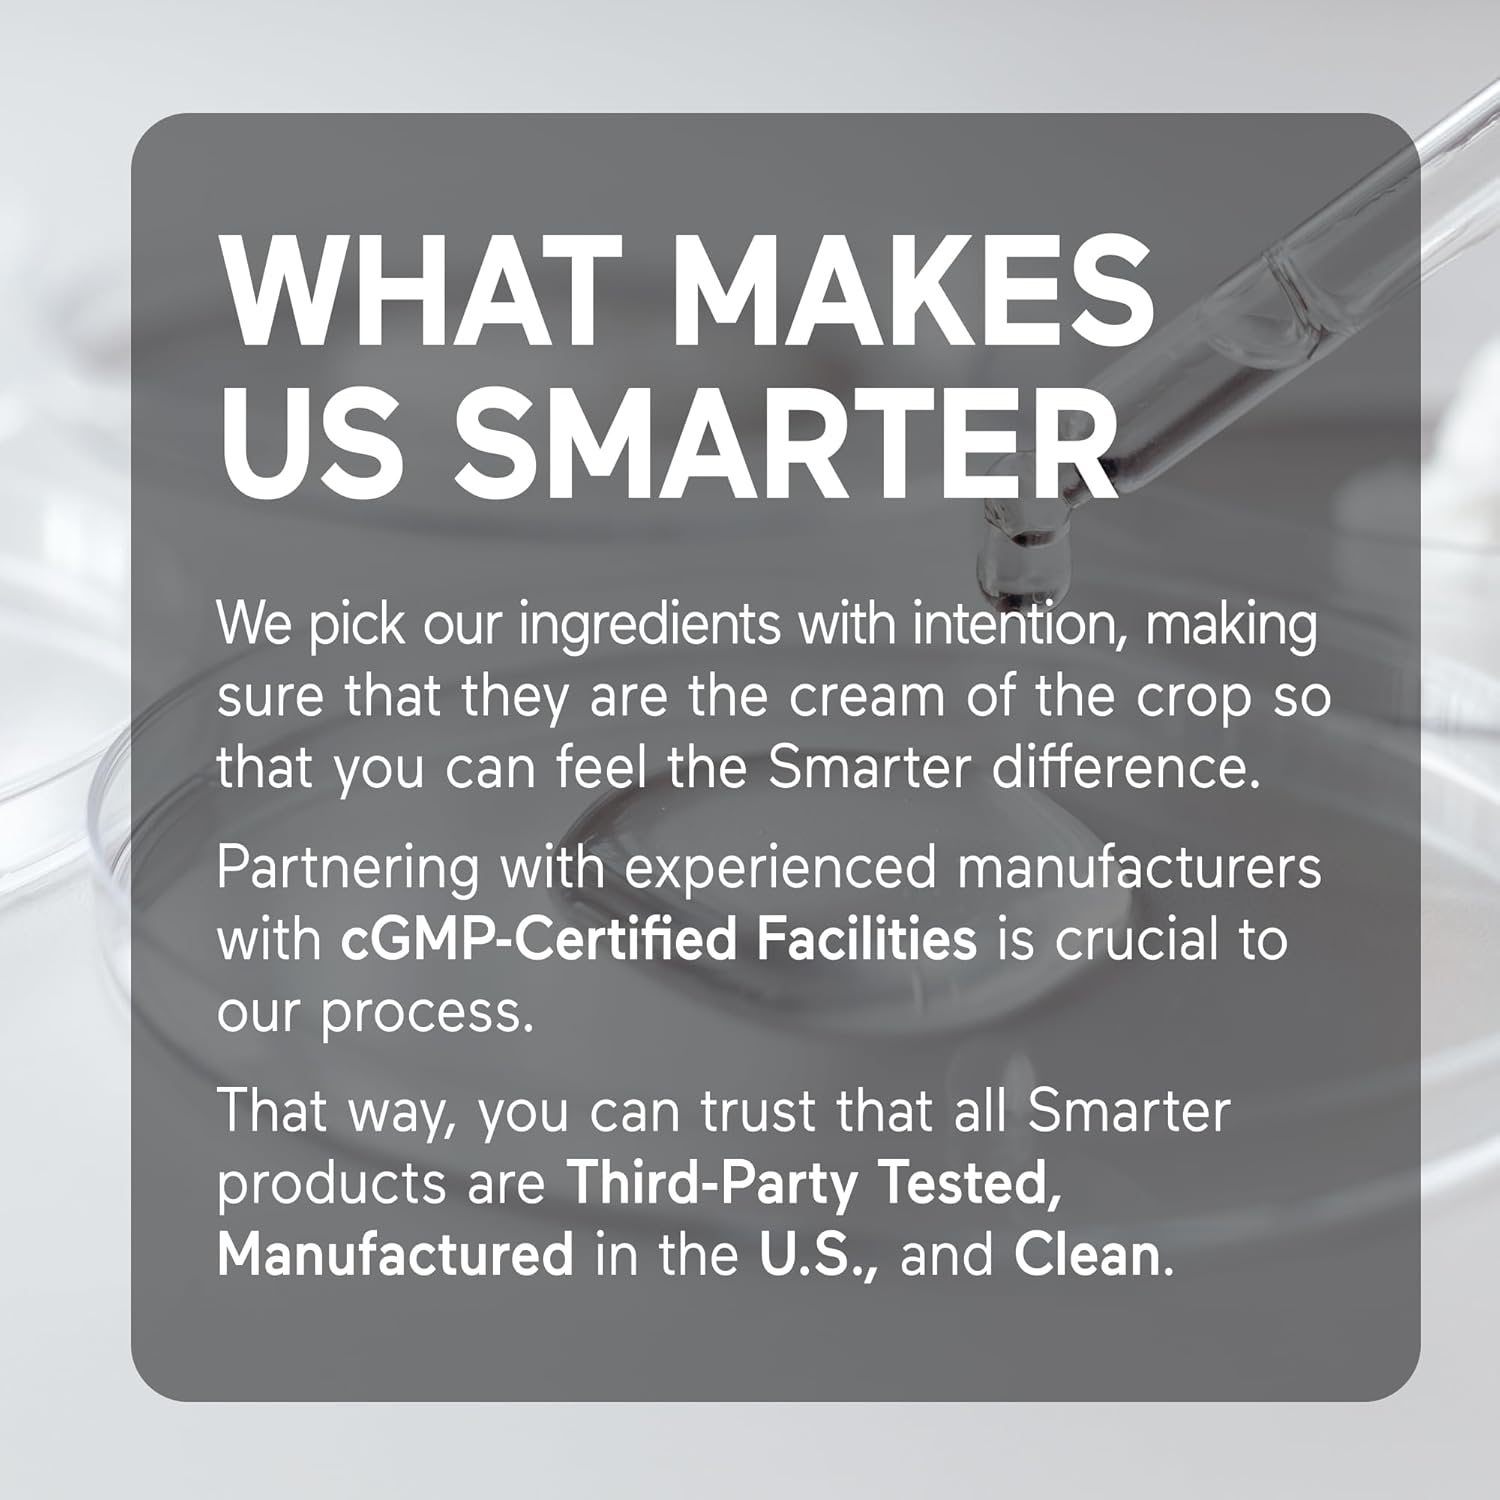
Smarter Nutrition Marine Magnesium Supplement 300mg - Naturally Sourced, Clinically Tested Magnesium + Avocado Oil & AstraGin for High Absorption - Non-GMO (90 Count (Pack of 1)) - Image 12

Smarter Nutrition Marine Magnesium Supplement 300mg - Naturally Sourced, Clinically Tested Magnesium + Avocado Oil & AstraGin for High Absorption - Non-GMO (90 Count (Pack of 1))
13 900 ֏
Mar. 9 - 12 In Armenia
Delivery & taxes included
Condition: new
Specifications
- NATURALLY SOURCED: Smarter Marine Magnesium is formulated with 300mg of Aquamin Magnesium, a natural mineral complex, with 72 trace minerals, sustainably derived from clean seawater in the Irish Sea.
- HIGH BIOAVAILABILITY: Aquamin Magnesium is clinically shown to have higher bioavailability than magnesium oxide, and higher solubility compared to magnesium glycinate and bisglycinate.*
- MUSCLE, BONE & SLEEP SUPPORT: Aquamin Magnesium is known for many benefits such as supporting muscle relaxation, bone health, quality sleep, and energy levels.*
- ENHANCED ABSORPTION: This magnesium supplement is formulated with Astragin, a natural compound derived from Astragalus and Panax notoginseng root that is clinically shown to support enhanced absorption of many vitamins, minerals and nutrients.*
- AVOCADO OIL: This magnesium supplement is also formulated with high-quality avocado oil to help support the absorption of magnesium, while providing a source of healthy fats and antioxidants.*
- Product Dimensions : 2.25 x 1.5 x 4.25 inches; 3.84 ounces
- Date First Available : June 25, 2025
- Manufacturer : Smarter Nutrition
- Customer Reviews: 4.3 4.3 out of 5 stars
13 900 ֏
Mar. 9 - 12 In Armenia
Delivery & taxes included
Condition: new
Specifications
Size
90 Count (Pack of 1)
![Smarter Nutrition Magnesium Complex - Chelated Magnesium Glycinate + Citrate, Malate for Sleep, Relaxation, Muscle & Nerves + Clinically Proven L-Theanine, Non-GMO-180 Tablet[90-Day Supply]](https://m.media-amazon.com/images/I/81YDkC2R9qL._AC_SL1500_.jpg)
![Smarter Nutrition Magnesium Complex - Chelated Magnesium Glycinate + Citrate, Malate for Sleep, Relaxation, Muscle & Nerves + Clinically Proven L-Theanine, Non-GMO-360 Tablet[180-Day Supply]](https://m.media-amazon.com/images/I/81w2soWnTNL._AC_UF480,480_SR480,480_.jpg)



